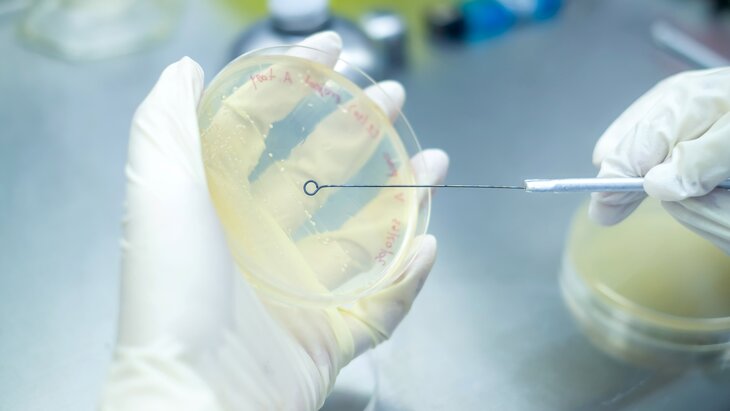

Попова исключила пандемию микоплазменной инфекции в РФ
Видео по теме
Фото: 123RF/pongchart
Глава Роспотребнадзора Анна Попова заявила, что новой пандемии, связанной с микоплазменной инфекцией, в России нет. Об этом сообщает радиостанция "Комсомольская правда".
"Это никакая не новая пандемия. Это отголоски пережитой нами пандемии, потому что она нанесла ущерб нашему иммунитету", – отметила глава ведомства.
По словам Поповой, в известных ученым штаммах микоплазменной инфекции нет мутаций. Оснований предполагать, что она стала полностью устойчивой к препаратам, в настоящее время нет.
Доцент кафедры инфекционных болезней РУДН Сергей Вознесенский ранее рассказал, что чаще всего во время болезни появляется температура, кашель и тяжесть при дыхании. Симптомами подобной инфекции также являются заложенный нос, боль в горле и интоксикация.
В свою очередь, глава российского Минздрава Михаил Мурашко заявил, что страна обеспечена достаточным количеством препаратов для лечения микоплазменной инфекции. Более того, отечественные медики имеют достаточно знаний о течении болезни, а также обладают возможностями для ее диагностики, добавил он.
"Жизнь в большом городе": сезон простуд